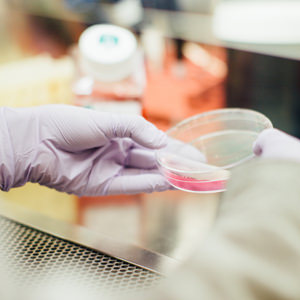
science camp

07/18/17 | Read Full Story >> Print
Thiel College, a leading liberal arts college in northwest Pennsylvania, received $175,000 recently from The Community Foundation of Western Pennsylvania & Eastern Ohio. The funds will go to continue the support of the Emerson A. Baughman, Agnes F. Baughman and David E. Baughman Endowed Scholarship at Thiel.

07/11/17 | Read Full Story >> Print
Thiel College President Susan Traverso, Ph.D., joined members of the Board of Trustees and alumni and about 100 other members of the Greenville community at the ribbon cutting for the new Cobblestones Suites & Hotel along 81 Hadley Road on Tuesday.

07/7/17 | Read Full Story >> Print
Historian, author and Thiel College President Susan Traverso, Ph.D., hopes recent developments and ongoing research into the 80-year-old mystery surrounding one of the College’s most famous honorary degree recipients, Amelia Earhart H’32, will call attention to and renew interest in the achievements of the aviation and women’s rights pioneer.

06/29/17 | Read Full Story >> Print
The research completed last summer by Thiel College Assistant Professor of Biology Christopher Fonner, Ph.D., on amphibian population decline has generated two new research questions during this summer’s Greenville Neuromodulation Center Faculty/Student Research Institute.

06/28/17 | Read Full Story >> Print
Thiel College James Pedas Professor of Media, Communication and Public Relations Dane S. Claussen, Ph.D., is one of only four U.S. scholars chosen for the Research Committee of the World Media Economics & Management Conference, to be held May 6-9, 2018, in Cape Town, South Africa. The Research Committee will be judging for acceptance abstracts of papers in August and accepting completed papers from mid-December until the end of January 2018.

06/23/17 | Read Full Story >> Print
Thiel College, a leading liberal arts college in northwest Pennsylvania, announced that it is accepting additional applications for The Marion G. Resch Science Scholarship program. Students can apply for one of five remaining scholarships that can be used as early as this fall.

06/20/17 | Read Full Story >> Print
Thiel College, a leading liberal arts college in northwest Pennsylvania, announces that Julie Neish, D.M.A., has been appointed to the Department of Performing Arts as director of choral activities and assistant professor of music.
06/14/17 | Read Full Story >> Print
Thiel College, a leading liberal arts college in northwest Pennsylvania, is sponsoring a weeklong science day camp for high school students on its campus starting June 19.

06/7/17 | Read Full Story >> Print
The Thiel College Cycling club is establishing a strong presence in the community this summer by encouraging service and leadership development.

06/5/17 | Read Full Story >> Print
Thiel College, a leading liberal arts college in northwest Pennsylvania, has begun the third summer of the Greenville Neuromodulation Center Faculty/Student Research Institute with projects from several faculty and student research teams studying such varied topics as the impact of threat on supporters of female politicians, adolescent nicotine exposure and amphibian skin bacteria.